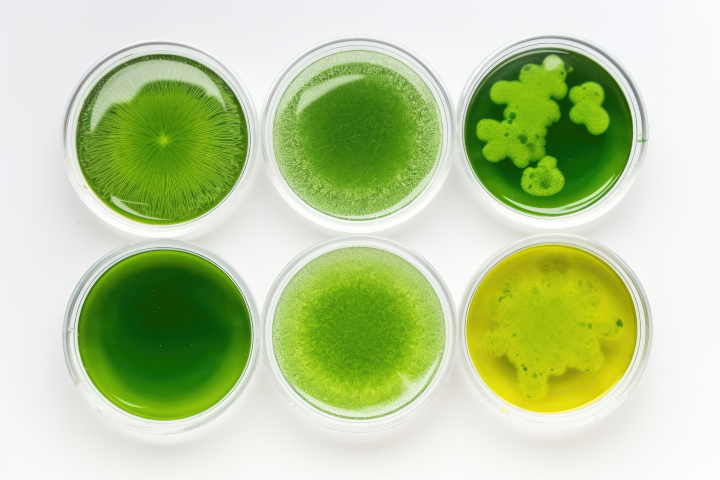
Bio Materials Engineering

Pioneering a New Era in Biotechnology
At Pneuma Research, we create groundbreaking solutions that empower industries, protect our planet, and redefine the boundaries of scientific possibility.
Discover Our VisionOur Mission
Pneuma Research is on a mission to revolutionize biotechnology through innovative, sustainable solutions. By combining cutting-edge technology with a passion for scientific discovery, we strive to solve the world's most pressing environmental and industrial challenges. From creating bioengineered materials to reducing atmospheric carbon, our vision is a healthier, more sustainable future for all.
Our Capabilities
Equipped with a state-of-the-art facility, Pneuma Research excels in biofabrication and green technology innovation. Our proprietary machinery includes advanced wet-spinning extruders, precision dip-coating baths, and high-resolution microscopy tools, enabling our highly skilled and talented team to push the boundaries of what's possible in materials science and biotechnology.
Research Activities
Bio Materials Engineering
Developing innovative biomaterials that enhance product performance and sustainability, paving the way for a greener tomorrow.

Sustainable Innovations
Designing eco-friendly technologies that transform industries while preserving the environment for future generations.

Carbon Reduction
Advancing research into carbon capture and utilization to combat climate change and restore balance to our planet.
Our Location
Located in North Carolina, Pneuma Research operates from a cutting-edge laboratory space affiliated with North Carolina State University. Our facilities are designed to foster collaboration, innovation, and excellence, making it the perfect environment to advance biotechnological discoveries.
